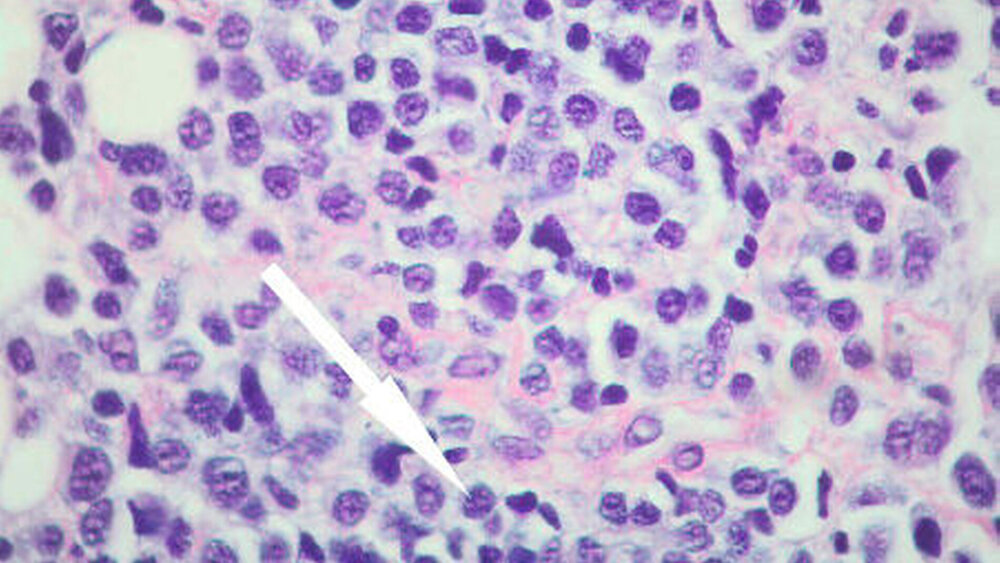

Klinische Manifestation eines Multiplen Myeloms
Maximilian Krüger, Christian Walter
Eine 81-jährige Frau wurde zur Zahnsanierung überwiesen. Die allgemeine Anamnese ergab ein Multiples Myelom vom Leichtketten-Typ (IgG lambda) mit Myelominfiltraten in Schädelkalotte, Kreuzbein sowie Lendenwirbelkörpern, weswegen seit vier Jahren mit Bisphosphonaten und dem RANK-Ligand-Antikörper Denosumab therapiert wurde. Außerdem waren ein systemischer Lupus erythematodes mit zerebraler Vaskulitis und Fibromyalgiesyndrom, ein Diabetes mellitus Typ II, ein parietales Meningeom sowie eine Schlafapnoe bekannt.
Im Bereich der rechten Stirn war zwei Wochen zuvor eine größenprogrediente nicht druckschmerzhafte Schwellung neu aufgetreten, die gegenüber der Unterlage verschieblich war und eine Größe von etwa zwei mal drei Zentimetern erreicht hatte (Abbildung 1).
Sonografisch war die Raumforderung teilweise unscharf begrenzt, bei weitestgehend hyposonorem, partiell unregelmäßigem Binnenecho (Abbildung 2).
Die enorale Untersuchung ergab bei unauffälliger Mundschleimhaut parodontal geschädigte und zweit- bis drittgradig gelockerte Zähne 17, 15, 37 und 46.
In der Panoramaschichtaufnahme zeigte sich ein generalisierter horizontaler Knochenabbau in Ober- und Unterkiefer. Des Weiteren sind eine relativ scharf begrenzte Transluzenz periradikulär um Zahn 37 sowie eine Verschattung im Bereich der rechten Kieferhöhle (Abbildung 3) erkennbar.
Unter perioperativer, antimikrobieller Prophylaxe erfolgten die Entnahme einer Probeexzision des Befunds der Stirn sowie die Extraktion der Zähne 17, 15, 37 und 46.
Das periapikal gelegene, bräunlich-bläulich veränderte Weichgewebe in regio 37 wurde in toto entfernt und ebenfalls der pathohistologischen Untersuchung zugeführt. Abschließend erfolgten die Glättung scharfer Knochenkanten und bei Bisphosphonat-anamnese die plastische Deckung.
Die feingewebliche Untersuchung bestätigte den Verdacht der Myelommanifestation im Unterkiefer und im Bereich der Stirn mit flächenhaften Infiltraten atypischer, plasmazytoider Zellen mit deutlich vergrößerten rundlich-ovalären und teilweise mehrkernigen Zellkernen (Abbildung 4).
Die ergänzenden immun-histochemischen Analysen ergaben intrazytoplasmatische Kappa- und Lambda-Leichtketten.
Im Rahmen der ambulanten Nachbehandlung fiel eine Woche nach Entlassung eine weitere, neu aufgetretene Schwellung im Bereich der Stirn auf.
Die Patientin ist weiter in onkologischer Anbindung zur Therapie des multiplen Myeloms.
Diskussion
Das Multiple Myelom gehört zu den B-Zell-Lymphomen und ist charakterisiert durch eine monoklonale Plasmazellvermehrung im Bereich des Knochenmarks. Durch die Plasmazellen werden komplette oder inkomplette monoklonale Antikörper ge- bildet, die als Paraprotein in Serum und Urin nachweisbar sind [Wörmann, 2010].
In Europa liegt die Inzidenz bei etwa vier bis fünf Erkrankungen auf 100 000 Einwohner, wobei Männer häufiger betroffen sind als Frauen. Interessanterweise sind dunkelhäutige Menschen deutlich häufiger betroffen. Der Altersgipfel liegt um die siebte Lebensdekade [Wörmann, 2010].
Neben dem typischen, multifokalen Befall des Knochenmarks gibt es Sonderformen wie das solitäre Plasmozytom in seiner ossären und extraossären Variante. In fortgeschrittenen Krankheitsstadien kann sich eine Plasmazell-Leukämie bilden, die mit einer schlechten Prognose einhergeht [Wörmann, 2010].
Zum Zeitpunkt der Diagnose sind etwa 20 Prozent der Patienten beschwerdefrei. Bei 60 Prozent liegen Blutbildveränderungen vor, wobei hier meist eine Anämie beschrieben wird. Weitere Symptome sind eine eingeschränkte körperliche Leistungsfähigkeit und aufgrund des sekundären Antikörpermangels eine gesteigerte Infektneigung. Typisch sind Knochenschmerzen meist im Bereich des Stammskeletts aufgrund der tumorbedingten Knochendestruktion, die zu pathologischen Frakturen führen können. Mit einher geht typischerweise eine Hyperkalzämie, die wiederum zur Polyurie führen kann. Anamnestisch wird über schäumenden Urin berichtet als Ausdruck der Proteinurie. Durch die Ablagerung der Proteine im Bereich der Niere (Amyloid) kann es zu einer progredienten Niereninsuffizienz kommen. Weitere häufig betroffene Organe sind das Herz, der Gastrointestinaltrakt und das Nervensystem.
Durch die Ablagerung der übermäßig produzierten Immunglobuline in den Nieren kann sich eine progrediente Niereninsuffizienz entwickeln [Wörmann, 2010].
Diagnosekriterien sind klonale Plasmazellen im Knochenmark, monoklonale Proteine in Serum und Urin, Endorganschädigungen und andere seltenere Manifestationen [Wörmann, 2010].
An Knochen sind in absteigender Häufigkeit Wirbelkörper, Schädel, Becken, Rippe sowie die langen Röhrenknochen befallen. Die Kiefer sind bei nahezu 30 Prozent aller Fälle befallen [Epstein et al., 1984], wobei der Unterkiefer häufiger befallen erscheint [Pisano et al., 1997].
Therapiert wird die Erkrankung mittels Chemotherapie sowie Cortison. In besonders schweren Fällen kann eine Stammzelltransplantation indiziert sein. Zum Verhindern von pathologischen Frakturen kann die Gabe von Bisphosphonaten angezeigt sein.
Eine Bestrahlungstherapie kommt im Rahmen palliativer Konzepte bei schmerzhaften Knochenläsionen zum Einsatz [Wörmann, 2010].
Im vorliegenden Fall war die Diagnose des Multiplen Myeloms bereits bekannt. Bei 16 Prozent der Myelompatienten erfolgt die Erstdiagnose aber aufgrund der Manifestation im Kiefer-Gesichtsbereich [Durie et al., 1975]. Führendes Symptom hierbei ist meist die nicht schmerzhafte Schwellung.
Radiologisch imponieren meist osteolytische Läsionen [Lae et al., 2003], die wie im vorliegenden Fall eine Parodontopathie imitieren können. Nach histologischer Sicherung mittels Biopsie sollte die Überweisung an eine hämato-onkologische Abteilung zur Durchführung des Stagings und der weiteren Therapie erfolgen.
Dr. Maximilian KrügerPD Dr. Dr. Christian Walter
Klinik und Poliklinik für Mund-, Kiefer- und Gesichtschirurgie – plastische OperationenUniversitätsmedizin der Johannes Gutenberg-Universität MainzAugustusplatz 2
55131 Mainz
Fazit für die Praxis
• Bei einem bekannten Multiplen Myelom muss vor zahnärztlich-chirurgischen Therapien die Frage der Bisphosphonateinnahme erfolgen.
• In 16 Prozent der Fälle manifestiert sich die Erkrankung zuerst im Kiefer- Gesichtsbereich mit dem Leitsymptom Schwellung. Der behandelnde Zahnarzt sollte das Erkrankungsbild kennen und in differenzialdiagnostische Überlegungen einbeziehen.
• Bei dem klinischen Verdacht auf Manifestation im Kieferbereich sollte nach bioptischer Diagnosesicherung die weitere Therapie durch eine Abteilung für Hämatologie erfolgen.